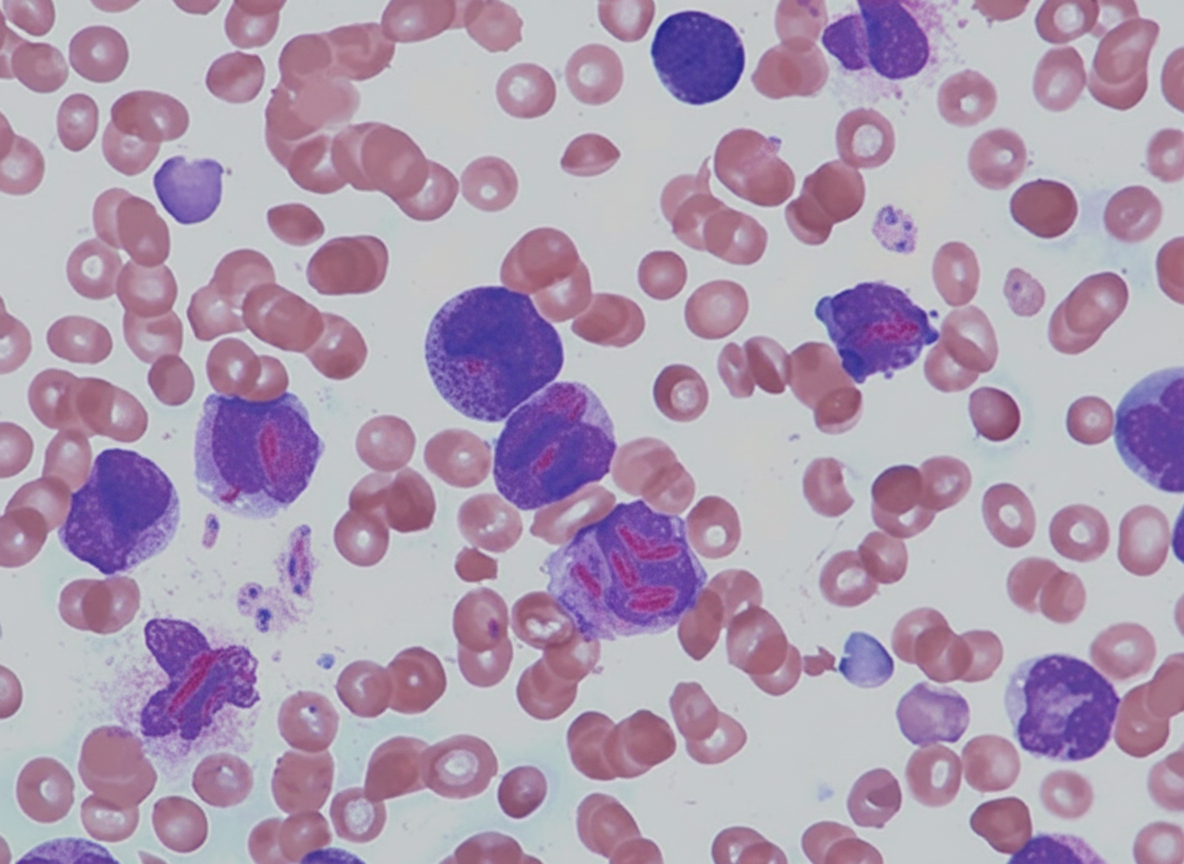
Image for question 639

A patient's urine contains a particular protein that appears normal at room temperature but turns dark upon standing. The dark color disappears upon heating. What condition is the patient most likely suffering from?
A 23-year-old female presented with jaundice and pallor for 2 months. Her peripheral blood smear shows the presence of spherocytes. What is the most relevant investigation to arrive at a diagnosis?
Which subtype of Acute Myeloid Leukemia (AML) is most commonly associated with gum hypertrophy?
What is the most common site of thrombosis in paroxysmal nocturnal hemoglobinuria?
Koilonchia is seen in which of the following conditions?
A 67-year-old man presents with 5 months of increasing weakness, fatigue, and weight loss. He has experienced decreasing vision in both eyes, headaches, and dizziness. His hands are sensitive to cold. Physical examination reveals generalized lymphadenopathy and hepatosplenomegaly. Laboratory studies show a serum protein level of 15.5 g/dL and an albumin concentration of 3.2 g/dL. A bone marrow biopsy shows infiltration by numerous small plasmacytoid lymphoid cells with Russell bodies in the cytoplasm. Which of the following additional laboratory findings is most likely to be reported for this patient?
Which of the following factors can differentiate primary polycythemia from secondary polycythemia?
What is the best treatment for Chronic Myeloid Leukemia (CML)?
What is the most likely subtype of leukemia associated with the provided finding?
Hemophilia B is due to deficiency of which coagulation factor?
Explanation: **Explanation:** The clinical scenario describes the classic physical property of **Bence-Jones proteins (BJP)**, which are monoclonal immunoglobulin light chains (either kappa or lambda) found in the urine of patients with **Multiple Myeloma** [1]. **The Underlying Concept:** Bence-Jones proteins exhibit unique thermal solubility. Unlike most proteins that coagulate permanently when heated, BJP: 1. Remains soluble at room temperature. 2. **Precipitates (turns dark/cloudy)** when heated to **40°C–60°C**. 3. **Redissolves (clears)** upon further heating to **100°C (boiling)**. 4. Re-precipitates upon cooling. This occurs because these light chains are small enough to be filtered by the glomerulus but exceed the reabsorptive capacity of the renal tubules. **Analysis of Options:** * **Multiple Myeloma (Correct):** A plasma cell dyscrasia characterized by the "M-spike" on electrophoresis and the presence of BJP in approximately 50-80% of cases [1]. Diagnosis of myeloma requires increased malignant plasma cells in the bone marrow and the presence of serum or urinary M-protein [1]. * **Osteoporosis (Incorrect):** While myeloma causes "punched-out" lytic bone lesions that may mimic osteoporosis, primary osteoporosis does not involve monoclonal protein production. * **Infectious Mononucleosis (Incorrect):** This is a viral infection (EBV) characterized by atypical lymphocytes (Downey cells) and heterophile antibodies, not light chain proteinuria. * **T-cell Tumor (Incorrect):** These typically involve cellular immunity defects; BJP is specifically a product of B-cell lineage (plasma cell) malignancy. **NEET-PG High-Yield Pearls:** * **Diagnosis:** BJP is **not** detected by standard urine dipsticks (which detect albumin). It requires **Sulphosalicylic Acid (SSA) test** or **Urine Protein Electrophoresis (UPEP)**. * **Renal Impact:** BJP is nephrotoxic and leads to "Myeloma Kidney" (Cast Nephropathy). * **CRAB Criteria:** Remember the hallmarks of Myeloma: **C**alcium (high), **R**enal failure, **A**nemia, **B**one lesions [1].
Explanation: **Explanation:** The presence of **spherocytes** on a peripheral blood smear in a patient with jaundice and pallor indicates extravascular hemolysis [1]. The two primary differential diagnoses for spherocytosis are **Hereditary Spherocytosis (HS)** and **Autoimmune Hemolytic Anemia (AIHA)** [1]. 1. **Why Coombs Test is the correct answer:** The most critical step in evaluating spherocytosis is to differentiate between an inherited membrane defect (HS) and an acquired immune-mediated process (AIHA). The **Direct Antiglobulin Test (Coombs test)** is the first-line investigation [1]. A positive result confirms AIHA, while a negative result points toward HS. Given the patient's age and presentation, ruling out an immune cause is the clinical priority [1]. 2. **Why other options are incorrect:** * **Osmotic Fragility Test:** While this test is classically associated with HS (showing increased fragility), it is **not specific**. Spherocytes in AIHA will also show increased osmotic fragility. Furthermore, it has been largely replaced by the Eosin-5-maleimide (EMA) binding test. * **Tests for PNH:** PNH typically presents with intravascular hemolysis and cytopenias [1]; the characteristic finding is "schistocytes" or normal morphology, not spherocytes. * **Reticulocyte Count:** This helps confirm that hemolysis is occurring (showing marrow response) but does not provide a specific diagnosis for the cause of spherocytosis. **Clinical Pearls for NEET-PG:** * **Spherocytes** lack central pallor because they have the lowest surface-area-to-volume ratio. * **MCHC** (Mean Corpuscular Hemoglobin Concentration) is typically **increased** (>36 g/dL) in spherocytosis [1]. * If the Coombs test is negative, the most sensitive modern test for Hereditary Spherocytosis is the **EMA Binding Test** (Flow cytometry).
Explanation: **Explanation:** The correct answer is **M4 (Acute Myelomonocytic Leukemia)**. **1. Why M4 is correct:** Gum hypertrophy (gingival hyperplasia) in AML is a classic clinical sign of **monocytic differentiation** [1]. In the FAB (French-American-British) classification, **M4 (Myelomonocytic)** and **M5 (Monocytic)** subtypes are characterized by the proliferation of monoblasts and monocytes. These cells have a high propensity to migrate out of the peripheral blood and infiltrate extramedullary tissues. The gingiva is a primary site for this infiltration, leading to swelling and hypertrophy [1]. **2. Why the other options are incorrect:** * **M1 (AML without maturation) & M2 (AML with maturation):** These are purely granulocytic lineages. While they are the most common subtypes of AML, they rarely present with extramedullary infiltration like gum hypertrophy. * **M3 (Acute Promyelocytic Leukemia):** This subtype is famously associated with **DIC (Disseminated Intravascular Coagulation)** due to the release of procoagulants from Auer rods. Its primary clinical concern is life-threatening hemorrhage, not tissue infiltration. **3. Clinical Pearls for NEET-PG:** * **M4/M5 Association:** Always look for "Gum Hypertrophy," "Skin Infiltration (Leukemia Cutis)," or "CNS involvement" in the clinical stem; these point toward M4 or M5 [1]. * **Cytogenetics:** M4eo (a variant of M4) is associated with **inv(16)** and has a relatively good prognosis. * **Enzyme Marker:** Monocytic lineages (M4/M5) are typically **Non-Specific Esterase (NSE) positive**, whereas granulocytic lineages (M1/M2/M3) are **Myeloperoxidase (MPO) positive**. * **M3 Hallmark:** Associated with **t(15;17)** and responds to **ATRA** (All-Trans Retinoic Acid).
Explanation: **Explanation:** **Paroxysmal Nocturnal Hemoglobinuria (PNH)** is an acquired clonal hematopoietic stem cell disorder characterized by a deficiency of glycosylphosphatidylinositol (GPI)-anchored proteins (like CD55 and CD59) due to a mutation in the **PIGA gene**. This deficiency leads to uncontrolled complement-mediated hemolysis and a profound prothrombotic state. **Why Intra-abdominal veins are correct:** Thrombosis is the leading cause of mortality in PNH (accounting for ~40% of deaths). Unlike the general population, where deep vein thrombosis (DVT) of the legs is most common, PNH has a unique predilection for **atypical sites**. The **intra-abdominal veins** (specifically the **hepatic vein**, leading to Budd-Chiari syndrome) are the most common sites of thrombosis. Other frequent sites include the portal, splenic, and mesenteric veins, as well as cerebral dural sinuses. **Why other options are incorrect:** * **A & D (Femoral and Saphenous veins):** While DVT can occur in PNH, these are the "typical" sites for thrombosis in the general population (e.g., post-surgery or immobilization). They are not the *most characteristic* or most common sites specific to the PNH disease process. * **B (Median cubital vein):** This is a superficial vein of the upper limb, usually associated with phlebitis due to IV cannulation, not the systemic hypercoagulable state of PNH. **High-Yield Clinical Pearls for NEET-PG:** * **Gold Standard Diagnosis:** Flow cytometry (shows absence of CD55/CD59). * **Classic Triad:** Hemolytic anemia, Pancytopenia, and Venous thrombosis. * **Treatment of Choice:** Eculizumab (a monoclonal antibody against C5 complement). * **Screening:** Always screen for PNH in patients presenting with unexplained Budd-Chiari syndrome or mesenteric ischemia.
Explanation: **Explanation:** **Koilonychia**, also known as "spoon-shaped nails," is a clinical sign characterized by the thinning and flattening of the nail plate, which eventually becomes concave with raised edges [1], [2]. 1. **Iron Deficiency Anaemia (IDA):** This is the most common cause of koilonychia [1]. The underlying mechanism is thought to be a deficiency of iron-containing enzymes in the epithelial cells of the nail bed, leading to impaired keratinization and structural weakening of the nail plate. It is a classic feature of chronic, severe IDA [1] and is also a component of **Plummer-Vinson Syndrome** (along with glossitis and esophageal webs). **Analysis of Incorrect Options:** * **Hypoalbuminemia:** Typically presents with **Muehrcke’s lines** (transverse white bands) or **Terry’s nails** (ground-glass appearance of the proximal nail bed), not spooning; whitening of the nail can also occur [2]. * **Lead Poisoning:** Classically associated with **Burtonian lines** (bluish-purple lines on the gingival margins) and basophilic stippling on peripheral smear, but does not typically affect nail curvature. * **Psoriasis:** Characterized by **nail pitting**, onycholysis (separation of the nail from the bed), and "oil spot" lesions. **NEET-PG High-Yield Pearls:** * **Plummer-Vinson Syndrome Triad:** Iron deficiency anemia, Atrophic glossitis, and Esophageal webs (increased risk of Squamous Cell Carcinoma). * **Other causes of Koilonychia:** Hemochromatosis (early stages), Raynaud’s disease, and high-altitude living. * **Infant Koilonychia:** It can be a normal physiological finding in the toenails of infants, usually resolving with age.
Explanation: This patient presents with a classic triad of **Waldenström Macroglobulinemia (WM)**: lymphadenopathy/hepatosplenomegaly, hyperviscosity symptoms (vision changes, headaches, dizziness), and a bone marrow biopsy showing **lymphoplasmacytic lymphoma** [1]. ### 1. Why Option D is Correct Waldenström Macroglobulinemia is a B-cell neoplasm characterized by the infiltration of the bone marrow by small lymphocytes showing plasma cell differentiation (plasmacytoid lymphocytes) [1]. These cells secrete a **monoclonal IgM protein**. Because IgM is a large pentamer, it significantly increases blood viscosity, leading to the "Hyperviscosity Syndrome" described (visual disturbances, neurological symptoms) [1]. The presence of **Russell bodies** (intracytoplasmic immunoglobulin inclusions) further supports a plasma cell dyscrasia. ### 2. Why Other Options are Incorrect * **A. Bence Jones proteinuria:** While seen in Multiple Myeloma (MM) [2], it is less characteristic of WM. In WM, the primary finding is the large IgM spike rather than free light chain excretion. * **B. Hypercalcemia:** This is a hallmark of Multiple Myeloma (part of the CRAB criteria) [2]. WM typically does **not** cause lytic bone lesions or hypercalcemia. * **C. t(14;18) translocation:** This is the genetic hallmark of **Follicular Lymphoma** (involving the BCL-2 gene). WM is more commonly associated with the **MYD88 L265P mutation**. ### 3. Clinical Pearls for NEET-PG * **Hyperviscosity Syndrome:** Think WM when you see "sausage-link" appearance on fundoscopy (dilated, tortuous retinal veins) [1]. * **Cold Agglutinin Disease:** WM is often associated with autoimmune hemolytic anemia (IgM mediated), explaining the patient's sensitivity to cold (Raynaud-like symptoms). * **Differentiating WM vs. MM:** * **WM:** IgM spike, Hepatosplenomegaly, Hyperviscosity, NO bone lesions [1]. * **MM:** IgG/IgA spike, Bone pain/Lytic lesions, Hypercalcemia, Renal failure [2].
Explanation: The fundamental difference between primary and secondary polycythemia lies in the **erythropoietin (EPO) drive**. **Primary Polycythemia (Polycythemia Vera)** is a myeloproliferative neoplasm (usually due to a JAK2 mutation) where the bone marrow produces excess red cells autonomously, independent of EPO levels [1]. In fact, EPO levels are typically low. **Secondary Polycythemia** is a physiological or pathological response to **hypoxia**. When arterial oxygen saturation drops (e.g., chronic lung disease, high altitude, or cyanotic heart disease), the kidneys sense the hypoxia and increase EPO production to stimulate erythropoiesis [1]. Therefore, **Alveolar oxygen tension (SaO2) <92% (or <90% in some clinical contexts)** is a hallmark of secondary polycythemia caused by hypoxemia. **Analysis of Incorrect Options:** * **A. Increased red cell mass:** This is the definition of absolute polycythemia and is present in **both** primary and secondary forms; hence, it cannot differentiate them [1]. * **C. Pneumonitis:** While lung inflammation can lead to hypoxia, it is a specific clinical condition rather than a diagnostic parameter used to classify polycythemia. * **D. Hypertension:** Hypertension is a common finding in Polycythemia Vera (due to hyperviscosity) but can also be seen in patients with secondary causes like Obstructive Sleep Apnea (OSA) or renal artery stenosis [1]. It is not a specific differentiating factor. **NEET-PG High-Yield Pearls:** * **JAK2 V617F mutation:** Present in >95% of Polycythemia Vera cases [1]. * **EPO Levels:** Low in Primary; High in Secondary polycythemia. * **Splenomegaly:** Highly suggestive of Primary Polycythemia (PV) [1]. * **Gaisbock Syndrome:** "Stress polycythemia" where red cell mass is normal but plasma volume is decreased (Relative Polycythemia) [1].
Explanation: **Explanation:** The treatment of Chronic Myeloid Leukemia (CML) is defined by the goal of therapy: long-term control versus a definitive cure. **Why Allogeneic BMT is the Correct Answer:** While Tyrosine Kinase Inhibitors (TKIs) like Imatinib are the **first-line medical management** for CML [1], **Allogeneic Bone Marrow Transplantation (BMT)** remains the only **curative** treatment modality. It involves replacing the patient's leukemic hematopoiesis with healthy donor stem cells, providing a "graft-versus-leukemia" effect [1]. In the context of standard medical exams like NEET-PG, when asked for the "best" or "curative" treatment, Allogeneic BMT is the preferred choice, especially for patients who fail TKI therapy or progress to blast crisis. **Analysis of Incorrect Options:** * **Autologous BMT:** This is not used in CML because the patient’s own bone marrow contains the Philadelphia chromosome ($t[9;22]$); re-infusing it would lead to a certain relapse. * **Alpha Interferon:** This was the treatment of choice before the advent of TKIs. It can induce cytogenetic remission but has significant side effects and is now considered second or third-line [1]. * **Hydroxyurea:** This is a myelosuppressive agent used only for **symptomatic control** (reducing high white cell counts) and does not affect the natural history of the disease or induce cytogenetic remission [1]. **High-Yield Clinical Pearls for NEET-PG:** * **First-line Drug of Choice:** Imatinib (TKI), which targets the BCR-ABL tyrosine kinase [1]. * **Cytogenetic Hallmark:** Philadelphia Chromosome $t(9;22)$, creating the *BCR-ABL* fusion gene [1]. * **Most Common Physical Finding:** Splenomegaly (often massive). * **Lab Diagnostic:** Low Leukocyte Alkaline Phosphatase (LAP) score (differentiates CML from a Leukemoid reaction).
Explanation: ***AML-M3*** - The finding shows **faggot cells** (promyelocytes with multiple bundled **Auer rods**), which is **pathognomonic** for AML-M3 (Acute Promyelocytic Leukemia). - Associated with **t(15;17) chromosomal translocation** and **PML-RARA fusion gene**, making it highly responsive to **all-trans retinoic acid (ATRA)** therapy. *B cell ALL* - Characterized by **lymphoblasts** with high nuclear-to-cytoplasmic ratio and **absent Auer rods**. - Typically affects **children** and presents with **lymphadenopathy** and **hepatosplenomegaly**. *AML-M4* - Shows **myeloblasts** and **monoblasts** with single Auer rods, not the characteristic **bundled Auer rods** seen in faggot cells. - Associated with **inv(16)** or **t(16;16)** chromosomal abnormalities and **eosinophilia**. *AML-M5* - Predominantly contains **monoblasts** and **promonocytes** with **folded nuclei** and abundant cytoplasm. - Auer rods are **rare or absent**, and cells lack the distinctive **faggot cell** morphology of AML-M3.
Explanation: **Explanation:** Hemophilia B, also known as **Christmas Disease**, is an X-linked recessive bleeding disorder caused by a deficiency of **Factor IX** [1]. Factor IX is a vitamin K-dependent serine protease that plays a critical role in the intrinsic pathway of the coagulation cascade, where it activates Factor X in the presence of Factor VIIIa, calcium, and phospholipids. **Analysis of Options:** * **Factor IX (Correct):** Deficiency leads to Hemophilia B. It is clinically indistinguishable from Hemophilia A but requires specific replacement with Factor IX concentrates [1]. * **Factor VIII (Incorrect):** Deficiency of Factor VIII causes **Hemophilia A** (Classic Hemophilia), which is the most common type of hemophilia (80-85% of cases) [1]. * **Factor VII (Incorrect):** Deficiency of Factor VII is rare and affects the **extrinsic pathway**, leading to an isolated prolongation of Prothrombin Time (PT). * **Factor X (Incorrect):** Deficiency of Factor X (Stuart-Prower factor) is a rare autosomal recessive disorder that affects the **common pathway**, prolonging both PT and aPTT. **High-Yield Clinical Pearls for NEET-PG:** * **Inheritance:** Both Hemophilia A and B are **X-linked recessive** (mostly affecting males) [1]. * **Lab Findings:** Characterized by **prolonged aPTT** with a **normal PT and bleeding time**. * **Mixing Study:** The prolonged aPTT corrects when the patient's plasma is mixed with normal plasma (indicating a factor deficiency rather than an inhibitor). * **Clinical Presentation:** Hallmark is **Hemarthrosis** (bleeding into joints, most commonly the knee) and muscle hematomas [1]. * **Treatment:** Factor IX concentrates or Fresh Frozen Plasma (FFP) if concentrates are unavailable [1]. Note that Cryoprecipitate does **not** contain Factor IX.
Anemia Evaluation and Management
Practice Questions
Hemoglobinopathies
Practice Questions
Thalassemias
Practice Questions
Platelet Disorders
Practice Questions
Coagulation Disorders
Practice Questions
Thrombotic Disorders
Practice Questions
Leukemias
Practice Questions
Lymphomas
Practice Questions
Multiple Myeloma and Plasma Cell Disorders
Practice Questions
Myeloproliferative Neoplasms
Practice Questions
Transfusion Medicine
Practice Questions
Hematopoietic Stem Cell Transplantation
Practice Questions
Get full access to all questions, explanations, and performance tracking.
Start For Free